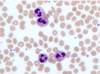
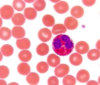

Histo: Fundamentals of Histology Flashcards
(24 cards)
Describe the appearane of neutrophils.
Multilobed nuclei with lots of granules
In what states might you seen an abundance of lymphomcytes?
Chronic inflammation
Lymphoma

Describe the appearance of eosinophils.
Bi-lobed nucleus with red granules
List three conditions that could cause eosinophilia.
Allergic reactions
Parasitic infections
Malignancy (Hodgkin’s Lymphoma)
Describe the appearance of the oesophagus in eosinophilc oesophagitis.
Horizontal striae are seen within the oesophagus (feline oesophagus)

Describe the appearance of mast cells.
Large cells containing a lot of granules

Describe the appearance of macrophages.
Large cells with lots of cytoplasm

In what states do macrophages tend to appear?
Late acute inflammation (macrophages clear up the debris)
Chronic inflammation (become secretory rather than phagocytic)
Define granuloma.
Organised collection of activated macrophages.
Describe the appearance of macrophages in granulomas.
Epithelioid macrophages - they have a lot of cytoplasm making them look like epithelial cells
What cytological feature is suggestive of a good sputum sample?
Pigmented macrophages - this suggests that they have come from the alveoli

What do macrophages in granulomas fuse together to form?
Langerhans giant cells

List some causes of granulomas.
- TB
- Leprosy
- Cat scratch fever
- Fungal infections
- Sarcoidosis
List three types of carcinoma.
- Squamous cell carcinoma
- Adenocarcinoma
- Transitional cell carcinoma
What are two key features of squamous cell carcinomas?
Keratin production
Intercellular bridges

What are two key features of adenocarcinomas?
Mucin production
Glands
Which stain is used for Melanin?
Fontana stain
What is the difference between a histochemical stain and an immunhistochemical stain?
- Histochemical stain - based on the chemical reaction between the stain and the tissue. The product will have a specific colour or other property that can be identified
- Immunhistochemical - involves using antibodies to detect a specific antigen within the tumour
What type of stain is haematoxylin and eosin?
Histochemical stain - one part will react with the acidic component of the tissue, the other part will react with the basic component
What stain is used for iron?
Prussion blue
Which stain is used for amyloid?
Congo red
When viewed under polarised light, it produces apple green birefringence
Describe the mechanism of:
- Immunofluorescence
- Immunoperoxidase
-
Immunofluorescence
- An antibody will be raisd against a particular antigen
- Another antibody will be raised against the Fc component of the previous antibody, this antibody will be attached to a fluorescence marker
- The first antibody will be to a specific antigen on the tissue and then the second antibody will bind to the first antibody - the flueorscence can then be detected
-
Immunoperoxidase
- An antibody is added to the tissue which binds to a particular antigen
- An enzyme is then added which binds to the antibody
- A substrate is then added which produces a product of a certain colour
What is a key immunological lymphoid marker?
CD45
What is a classic histological feature of HSV infection?
Cells with multiple nuclei
(Multinucleated giant cells)



